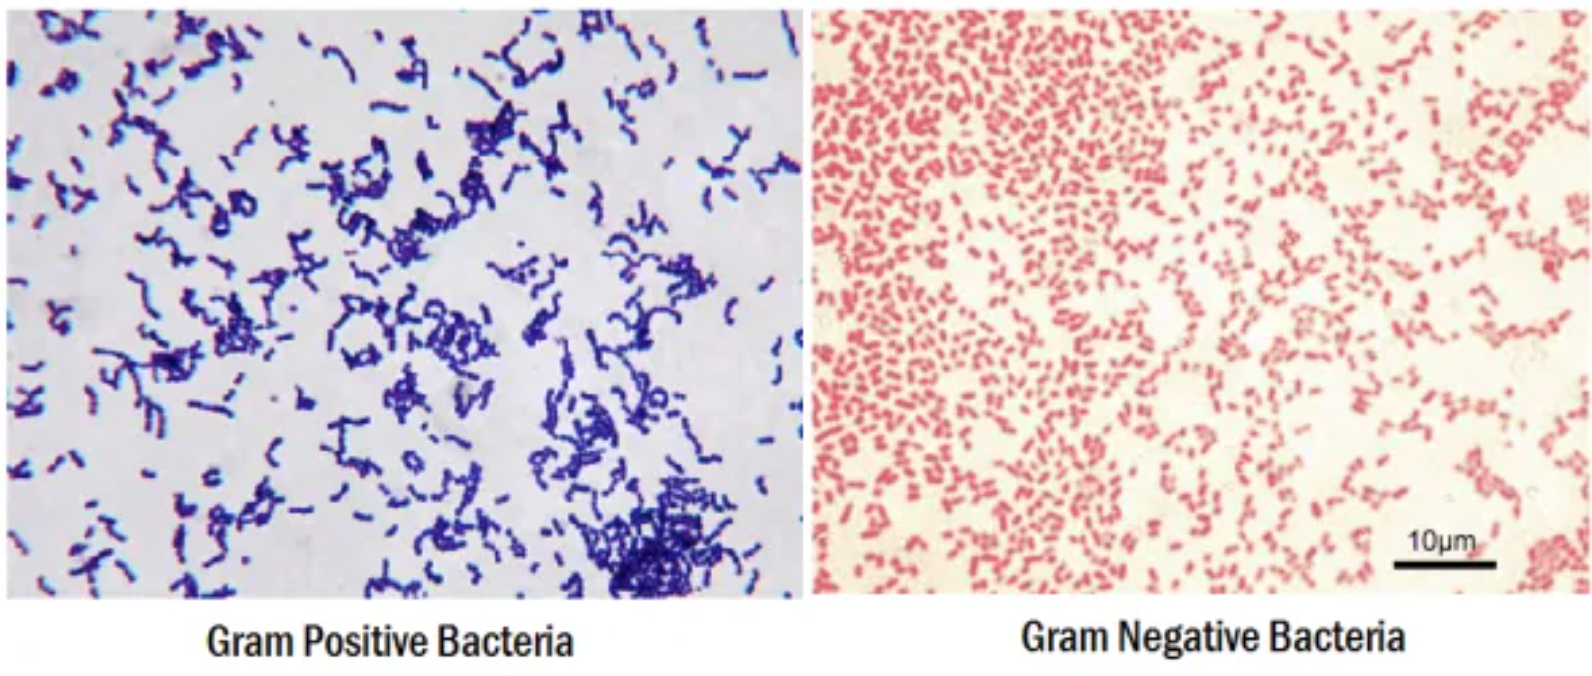

Грамотрицательные бактерии представители
Краска 9 73
Уведомление о подтверждении использования
Погода нязепетровск 10 дней самый точный прогноз
Числовые наборы и среднее арифметическое 8 класс
Ноутбук dell белый
Takata дассен
Как найти долю пшеницы
Расслабляющие релакс мелодии
Зима отменяется
Расов кинг
Козинаки из перловки
Легкий ланч
Лучшие ст танки 2025
Грамотрицательные бактерии представители 53 фото